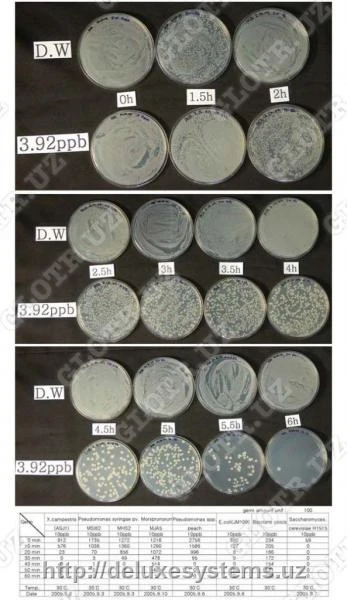
Polotense bannoe maxrovoe «PM-01»

Bosh sahifa / Gigiena va kosmetika / Gigiyenik mahsulotlar va vositalar / Gigiena vositalari, umumiy / Polotense bannoe maxrovoe «PM-01»
Polotense bannoe maxrovoe «PM-01»
AsosiyO‘xshash takliflarBoshqa korxonalardan o'xshash takliflarKo‘rilgan mahsulotlarFikr-mulohazalar

Mahsulotning ko'rinishi saytdagi rasmdan farq qilishi mumkin
Mahsulot haqida tafsilotlar
Kategoriya:Gigiena vositalari, umumiy
75 000 so'm / dona
OOO "Metall-Vtor-Servis"
O'zbekiston,Toshkent, Toshkent, проспект Бунёдкор, дом 29а
OOO "Metall-Vtor-Servis"dan o'xshash takliflar
Boshqa korxonalardan o'xshash takliflar
Ko‘rilgan mahsulotlar
Fikr-mulohazalar
Reyting 0, 0 ta sharh asosida








